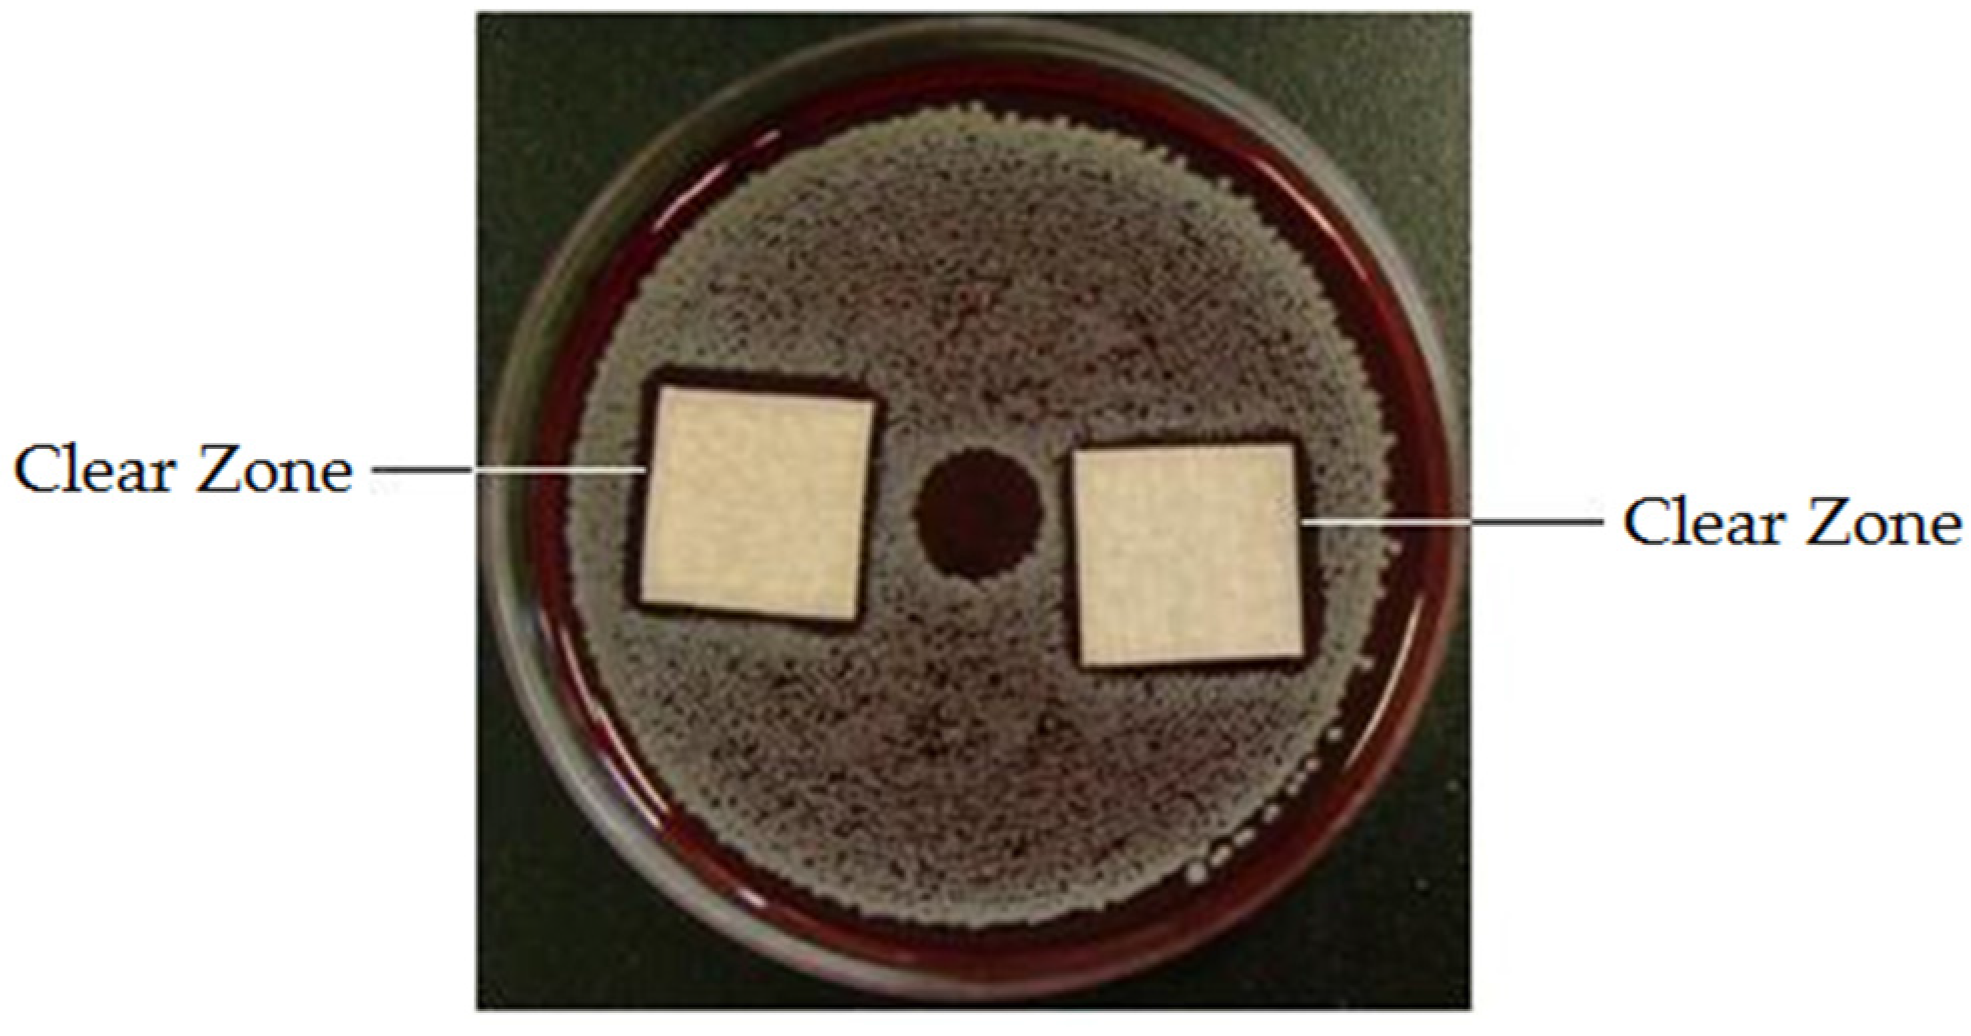
Coatings 07 00011 g003 550

Regenerable Antibacterial Cotton Fabric by Plasma Treatment with Dimethylhydantoin: Antibacterial Activity against S. aureus
Abstract
:1. Introduction
2. Experimental Methods
2.1. Fabric and Chemicals
2.2. Plasma Treatment
2.3. Optimising the Treatment Condition for Coating DMH on Cotton Fabric
2.4. Antibacterial Property
2.5. Active Chlorine Content of Chlorinated DMH Coated in Cotton Fabric
2.6. Regenerability
2.6.1. Chemical Composition of DMH Coated Fabric
2.6.2. Scanning Electron Microscopy (SEM)
2.6.3. Tearing Strength
3. Results
3.1. Optimised Treatment Condition for Antibacterial Finishing
3.2. Relationship between the Antibacterial Property and the Concentration of Chlorine on Cotton Fabric
3.3. Regenerability
3.4. FTIR-ATR
3.5. SEM
3.6. Tearing Strength
4. Discussion
5. Conclusions
Acknowledgments
Author Contributions
Conflicts of Interest
References
- Thanh, N.V.K.; Phong, N.T.P. Investigation of antibacterial activity of cotton fabric incorporating nano silver colloid. J. Phys. 2009, 187, 1–7. [Google Scholar] [CrossRef]
- Kenawy, E.; Abdel-Fattah, Y.R. Antimicrobial properties of modified and electrospun poly (vinyl phenol). Macromol. Biosci. 2002, 2, 261–266. [Google Scholar] [CrossRef]
- Lala, N.L.; Ramaseshan, R.; Bojun, L.; Sundarrajan, S.; Barhate, R.S.; Ying-Jun, L.; Ramakrishna, S. Fabrication of nanofibers with antimicrobial functionality used as filters: Protection against bacterial contaminants. Biotechnol. Bioeng. 2007, 97, 1357–1365. [Google Scholar] [CrossRef] [PubMed]
- Gouda, M.; Ibrahim, N. New approach for improving antibacterial functions of cotton fabric. J. Ind. Text. 2008, 37, 327–339. [Google Scholar] [CrossRef]
- Lim, S.; Hudson, S.M. Application of a fiber-reactive chitosan derivative to cotton fabric as an antimicrobial textile finish. Carbohydr. Polym. 2004, 56, 227–234. [Google Scholar] [CrossRef]
- Abidi, N.; Hequet, E.; Cabrales, L. Changes in sugar composition and cellulose content during the secondary cell wall biogenesis in cotton fibers. Cellulose 2010, 17, 153–160. [Google Scholar] [CrossRef]
- Chen, S.; Chen, S.; Jiang, S.; Xiong, M.; Luo, J.; Tang, J.; Ge, Z. Environmentally friendly antibacterial cotton textiles finished with siloxane sulfopropylbetaine. ACS Appl. Mater. Interfaces 2011, 3, 1154–1162. [Google Scholar] [CrossRef] [PubMed]
- Sun, G.; Xu, X.; Bickett, J.R.; Williams, J.F. Durable and regenerable antibacterial finishing of fabrics with a new hydantoin derivative. Ind. Eng. Chem. Res. 2001, 40, 1016–1021. [Google Scholar] [CrossRef]
- Liu, S.; Sun, G. Durable and regenerable biocidal polymers: Acyclic N-halamine cotton cellulose. Ind. Eng. Chem. Res. 2006, 45, 6477–6482. [Google Scholar] [CrossRef]
- Ye, W.; Xin, J.H.; Li, P.; Lee, K.D.; Kwong, T. Durable antibacterial finish on cotton fabric by using chitosan-based polymeric core-shell particles. J. Appl. Polym. Sci. 2006, 102, 1787–1793. [Google Scholar] [CrossRef]
- Son, Y.; Kim, B.; Ravikumar, K.; Lee, S. Imparting durable antimicrobial properties to cotton fabrics using quaternary ammonium salts through 4-aminobenzenesulfonic acid-chloro-triazine adduct. Eur. Polym. J. 2006, 42, 3059–3067. [Google Scholar] [CrossRef]
- Hebeish, A.; El-Naggar, M.E.; Fouda, M.M.G.; Ramadan, MA.; Al-Deyab, S.S.; El-Rafie, M.H. Highly effective antibacterial textiles containing green synthesized silver nanoparticles. Carbohydr. Polym. 2011, 86, 936–940. [Google Scholar] [CrossRef]
- Lee, H.; Yeo, S.; Jeong, S. Antibacterial effect of nanosized silver colloidal solution on textile fabrics. J. Mater. Sci. 2003, 38, 2199–2204. [Google Scholar] [CrossRef]
- Perelshtein, I.; Applerot, G.; Perkas, N.; Wehrschuetz-Sigl, E.; Hasmann, A.; Guebitz, G.; Gedanken, A. CuO-cotton nanocomposite: Formation, morphology, and antibacterial activity. Surf. Coat. Technol. 2009, 204, 54–57. [Google Scholar] [CrossRef]
- Jia, B.; Mei, Y.; Cheng, L.; Zhou, J.; Zhang, L. Preparation of copper nanoparticles coated cellulose films with antibacterial properties through one-step reduction. ACS Appl. Mater. Interfaces 2012, 4, 2897–2902. [Google Scholar] [CrossRef] [PubMed]
- Leroux, F.; Perwuelz, A.; Campagne, C.; Behary, N. Atmospheric air-plasma treatments of polyester textile structures. J. Adhes. Sci. Technol. 2006, 20, 939–957. [Google Scholar] [CrossRef]
- Zhou, C.E.; Kan, C.W. Plasma-assisted regenerable chitosan antimicrobial finishing for cotton. Cellulose 2014, 21, 2951–2962. [Google Scholar] [CrossRef]
- Hegemann, D. Plasma polymerization and its applications in textiles. Indian J. Fibre Text. Res. 2006, 31, 99–115. [Google Scholar]
- Bertaux, E.; Le Marec, E.; Crespy, D.; Rossi, R.; Hegemann, D. Effects of siloxane plasma coating on the frictional properties of polyester and polyamide fabrics. Surf. Coat. Technol. 2009, 204, 165–171. [Google Scholar] [CrossRef]
- Abidi, N.; Hequet, E. Cotton fabric graft copolymerization using microwave plasma. I. Universal attenuated total reflectance-FTIR study. J. Appl. Polym. Sci. 2004, 93, 145–154. [Google Scholar] [CrossRef]
- Virk, R.K.; Ramaswamy, G.N.; Bourham, M.; Bures, B.L. Plasma and antimicrobial treatment of nonwoven fabrics for surgical gowns. Text. Res. J. 2004, 74, 1073–1079. [Google Scholar] [CrossRef]
- Morent, R.; De Geyter, N.; Verschuren, J.; De Clerck, K.; Kiekens, P.; Leys, C. Non-thermal plasma treatment of textiles. Surf. Coat. Technol. 2008, 202, 3427–3449. [Google Scholar] [CrossRef]
- Zhou, C.E.; Kan, C.W.; Yuen, C.W.M.; Lo, K.Y.C.; Ho, C.P.; Lau, K.W.R. Regenerable antimicrobial finishing of cotton with nitrogen plasma treatment. BioResources 2016, 11, 1554–1570. [Google Scholar] [CrossRef]
- Zhou, C.E.; Kan, C.W. Plasma-enhanced regenerable 5,5-dimethylhydantoin (DMH) antibacterial finishing for cotton fabric. Appl. Surf. Sci. 2015, 328, 410–417. [Google Scholar] [CrossRef]
- Zhou, C.E.; Kan, C.W. Optimizing rechargeable antimicrobial performance of cotton fabric coated with 5,5-dimethylhydantoin (DMH). Cellulose 2015, 22, 879–886. [Google Scholar] [CrossRef]
- Zhou, C.E.; Kan, C.W.; Yuen, C.W.M. Orthogonal analysis for rechargeable antimicrobial finishing of plasma pretreated cotton. Cellulose 2015, 22, 3465–3475. [Google Scholar] [CrossRef]
- Zhou, C.E.; Kan, C.W.; Yuen, C.W.M.; Matinlinna, J.P.; Tsoi, J.K.H.; Zhang, Q. Plasma treatment applied in the pad-dry-cure process for making rechargeable antimicrobial cotton fabric that inhibits S. Aureus. Text. Res. J. 2015, 86, 2202–2215. [Google Scholar] [CrossRef]
- Kan, C.W. Evaluating antistatic performance of plasma-treated polyester. Fibers Polym. 2007, 8, 629–634. [Google Scholar] [CrossRef]
- Kan, C.W.; Yuen, C.W.M.; Wong, W.Y. Optimizing color fading effect of cotton denim fabric by enzyme treatment. J. Appl. Polym. Sci. 2011, 120, 3596–3603. [Google Scholar] [CrossRef]
- Sathianarayanan, M.; Bhat, N.; Kokate, S.; Walunj, V. Antibacterial finish for cotton fabric from herbal products. Indian J. Fibre Text. Res. 2010, 35, 50–58. [Google Scholar]
- Scholz, J.; Nocke, G.; Hollstein, F.; Weissbach, A. Investigations on fabrics coated with precious metals using the magnetron sputter technique with regard to their anti-microbial properties. Surf. Coat. Technol. 2005, 192, 252–256. [Google Scholar] [CrossRef]
- Mohammadkhodaei, Z.; Mokhtari, J.; Nouri, M. Novel anti-bacterial acid dyes derived from naphthalimide: Synthesis, characterisation and evaluation of their technical properties on nylon 6. Coloration Technol. 2010, 126, 81–85. [Google Scholar] [CrossRef]
- Daoud, W.A.; Xin, J.H.; Tao, X.M. Superhydrophobic silica nanocomposite coating by a low-temperature process. J. Am. Ceram. Soc. 2004, 87, 1782–1784. [Google Scholar] [CrossRef]
- Chuanwen, C.; Feng, S.; Yuguo, L.; Shuyun, W. Orthogonal analysis for perovskite structure microwave dielectric ceramic thin films fabricated by the RF magnetron-sputtering method. J. Mater. Sci. 2010, 21, 349–354. [Google Scholar] [CrossRef]
- Kocer, H.B.; Akdag, A.; Ren, X.; Broughton, R.M.; Worley, S.D.; Huang, T.S. Effect of alkyl derivatization on several properties of N-halamine antimicrobial siloxane coatings. Ind. Eng. Chem. Res. 2008, 47, 7558–7563. [Google Scholar] [CrossRef]
- Qian, L.; Sun, G. Durable and regenerable antimicrobial textiles: Synthesis and applications of 3-methylol-2,2,5,5-tetramethyl-imidazolidin-4-one (MTMIO). J. Appl. Polym. Sci. 2003, 89, 2418–2425. [Google Scholar] [CrossRef]
- Wang, L.; Xie, J.; Gu, L.; Sun, G. Preparation of antimicrobial polyacrylonitrile fibers: Blending with polyacrylonitrile-co-3-allyl-5,5-dimethylhydantoin. Polym. Bull. 2006, 56, 247–256. [Google Scholar] [CrossRef]
- El-Newehy, M.H.; Al-Deyab, S.S.; Kenawy, E.; Abdel-Megeed, A. Nanospider technology for the production of nylon-6 nanofibers for biomedical applications. J. Nanomater. 2011, 2011, 626589. [Google Scholar] [CrossRef]
- Sun, X.; Cao, Z.; Porteous, N.; Sun, Y. An N-halamine-based rechargeable antimicrobial and biofilm controlling polyurethane. Acta Biomater. 2012, 8, 1498–1506. [Google Scholar] [CrossRef] [PubMed]
- Kocer, H.B.; Worley, S.; Broughton, R.; Huang, T. A novel N-halamine acrylamide monomer and its copolymers for antimicrobial coatings. React. Funct. Polym. 2011, 71, 561–568. [Google Scholar] [CrossRef]
- Yoon, N.S.; Lim, Y.J.; Tahara, M.; Takagishi, T. Mechanical and dyeing properties of wool and cotton fabrics treated with low temperature plasma and enzymes. Text. Res. J. 1996, 66, 329–336. [Google Scholar] [CrossRef]
- Wong, K.K.; Tao, X.M.; Yuen, C.W.M.; Yeung, K.W. Low temperature plasma treatment of linen. Text. Res. J. 1999, 69, 846–855. [Google Scholar] [CrossRef]
- Silva, S.S.; Luna, S.M.; Gomes, M.E.; Benesch, J.; Pashkuleva, I.; Mano, J.F.; Reis, R.L. Plasma surface modification of chitosan membranes: Characterization and preliminary cell response studies. Macromol. Biosci. 2008, 8, 568–576. [Google Scholar] [CrossRef] [PubMed]
- Max, J.J.; Chapados, C. Infrared spectroscopy of aqueous carboxylic acids: Comparison between different acids and their salts. J. Phys. Chem. A 2004, 108, 3324–3337. [Google Scholar] [CrossRef]
- Karahan, H.; Özdoğan, E. Improvements of surface functionality of cotton fibers by atmospheric plasma treatment. Fibers Polym. 2008, 9, 21–26. [Google Scholar] [CrossRef]
- Cheng, S.Y.; Yuen, C.W.M.; Kan, C.W.; Cheuk, K.K.L.; Daoud, W.A.; Lam, P.L.; Tsoi, W.Y.I. Influence of atmospheric pressure plasma treatment on various fibrous materials: Performance properties and surface adhesion analysis. Vacuum 2010, 84, 1466–1470. [Google Scholar] [CrossRef]
- Kan, C.W.; Chan, K.; Yuen, C.W.M. A study of the oxygen plasma treatment on the serviceability of a wool fabric. Fibers Polym. 2004, 5, 213–218. [Google Scholar] [CrossRef]
- Sun, G.; Worley, S.D. Chemistry of durable and regenerable biocidal textiles. J. Chem. Educ. 2005, 82, 60–64. [Google Scholar] [CrossRef]

| Level | Variables | |||
|---|---|---|---|---|
| Concentration of DMH (%) | Curing Temperature (°C) | Concentration of Bleaching Solution (%) | Time of Chlorination (min) | |
| A | B | C | D | |
| I | 2 | 120 | 0.8 | 20 |
| II | 4 | 140 | 1.0 | 40 |
| III | 6 | 160 | 1.2 | 60 |
| Test Run | Variables | |||
|---|---|---|---|---|
| Concentration of DMH (%) | Curing Temperature (°C) | Concentration of Bleaching Solution (%) | Time of Chlorination (min) | |
| A | B | C | D | |
| 1 | I | I | I | I |
| 2 | I | II | II | II |
| 3 | I | III | III | III |
| 4 | II | I | II | III |
| 5 | II | II | III | I |
| 6 | II | III | I | II |
| 7 | III | I | II | II |
| 8 | III | II | I | III |
| 9 | III | III | II | I |
| Test Run | Parameters | Results | |||
|---|---|---|---|---|---|
| Concentration of DMH (%) | Temperature of Curing (°C) | Concentration of Bleaching Solution (%) | Time of Chlorination (min) | Mean clear width against S. aureus (mm) | |
| A | B | C | D | wi | |
| 1 | I | I | I | I | 1.156 |
| 2 | I | II | II | II | 1.090 |
| 3 | I | III | III | III | 1.611 |
| 4 | II | I | II | III | 1.062 |
| 5 | II | II | III | I | 1.338 |
| 6 | II | III | I | II | 0.879 |
| 7 | III | I | III | II | 1.468 |
| 8 | III | II | I | III | 1.601 |
| 9 | III | III | II | I | 1.258 |
| TmI | 3.857 | 3.686 | 3.636 | 3.752 | Tmn = = 1wi |
| TmII | 3.279 | 4.029 | 3.410 | 3.437 | – |
| TmIII | 4.327 | 3.748 | 4.417 | 4.274 | Kmn = 1/3Tmn = 1/3 = 1wi |
| KmI | 1.286 | 1.229 | 1.212 | 1.251 | – |
| KmII | 1.093 | 1.343 | 1.137 | 1.146 | – |
| KmIII | 1.442 | 1.249 | 1.472 | 1.425 | – |
| R | 0.349 | 0.114 | 0.335 | 0.279 | R = Max(KmI, KmII, KmIII) − Min(KmI, KmII, KmIII) |
| Sample | Untreated | CD | CDPD |
|---|---|---|---|
| Tearing strength in warp direction (N) | 15.42 | 14.63 | 14.60 |
| Tearing strength in weft direction (N) | 10.4 | 9.42 | 9.60 |
© 2017 by the authors; licensee MDPI, Basel, Switzerland. This article is an open access article distributed under the terms and conditions of the Creative Commons Attribution (CC-BY) license (http://creativecommons.org/licenses/by/4.0/).
Share and Cite
Zhou, C.-E.; Kan, C.-w.; Matinlinna, J.P.; Tsoi, J.K.-h. Regenerable Antibacterial Cotton Fabric by Plasma Treatment with Dimethylhydantoin: Antibacterial Activity against S. aureus. Coatings 2017, 7, 11. https://doi.org/10.3390/coatings7010011
Zhou C-E, Kan C-w, Matinlinna JP, Tsoi JK-h. Regenerable Antibacterial Cotton Fabric by Plasma Treatment with Dimethylhydantoin: Antibacterial Activity against S. aureus. Coatings. 2017; 7(1):11. https://doi.org/10.3390/coatings7010011
Chicago/Turabian StyleZhou, Chang-E., Chi-wai Kan, Jukka Pekka Matinlinna, and James Kit-hon Tsoi. 2017. "Regenerable Antibacterial Cotton Fabric by Plasma Treatment with Dimethylhydantoin: Antibacterial Activity against S. aureus" Coatings 7, no. 1: 11. https://doi.org/10.3390/coatings7010011
APA StyleZhou, C.-E., Kan, C.-w., Matinlinna, J. P., & Tsoi, J. K.-h. (2017). Regenerable Antibacterial Cotton Fabric by Plasma Treatment with Dimethylhydantoin: Antibacterial Activity against S. aureus. Coatings, 7(1), 11. https://doi.org/10.3390/coatings7010011

